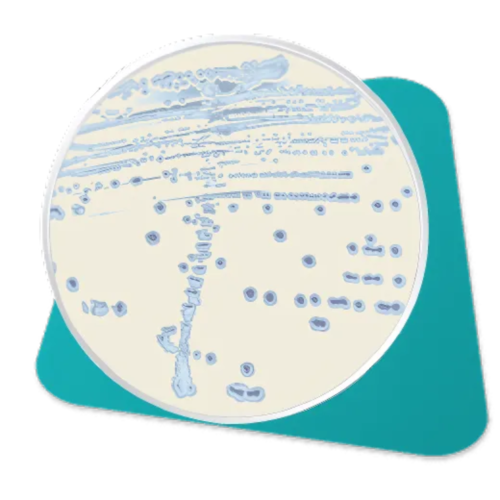
Agar Cromogênico ESBL Placa De Cultura Pronta 90x15 C/10 Advagen

| 
× | 
  | 
Seringa 10ml De Segurança NO GAP Luer Lock - Sol Care C/100 | 
R$298,28 | 
  | 
R$298,28 | 
| 
× | 
  | 
Tubo De Coleta Vácuo Edta 2ml K3 Kit C/300 – Vacuplast | 
R$309,23 | 
  | 
R$309,23 | 
| 
× | 
  | 
Kit Seringa Hipodérmica 3mL Luer Lock + Agulha 21g (25x0,8) C/100 - Medix | 
R$65,90 | 
  | 
R$65,90 | 
| 
× |
| 
Agar Cromogênico ESBL Placa De Cultura Pronta 90x15 C/10 Advagen | 
R$119,73 | 
  | 
R$119,73 | 
| 
× | 
  | 
Kit Coloração Panótico Rápido Conjunto 3x500ml - New Prov | 
R$85,88 | 
  | 
R$85,88 | 
| 
× | 
  | 
Teste Rápido De Hiv 1/2 Kit Econômico C/50 - Deep Blue | 
R$240,00 | 
  | 
R$240,00 | 
| 
× | 
  | 
Seringa Para Gasometria C/ Agulha Com Heparina Litica 2,5ml C/100 - Neolab | 
R$287,50 | 
  | 
R$287,50 | 
| 
 |